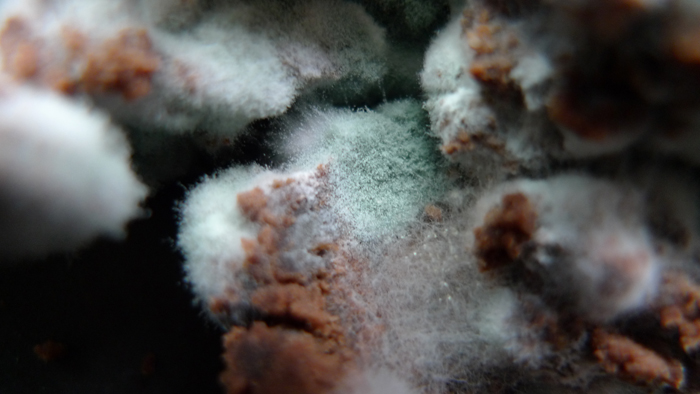
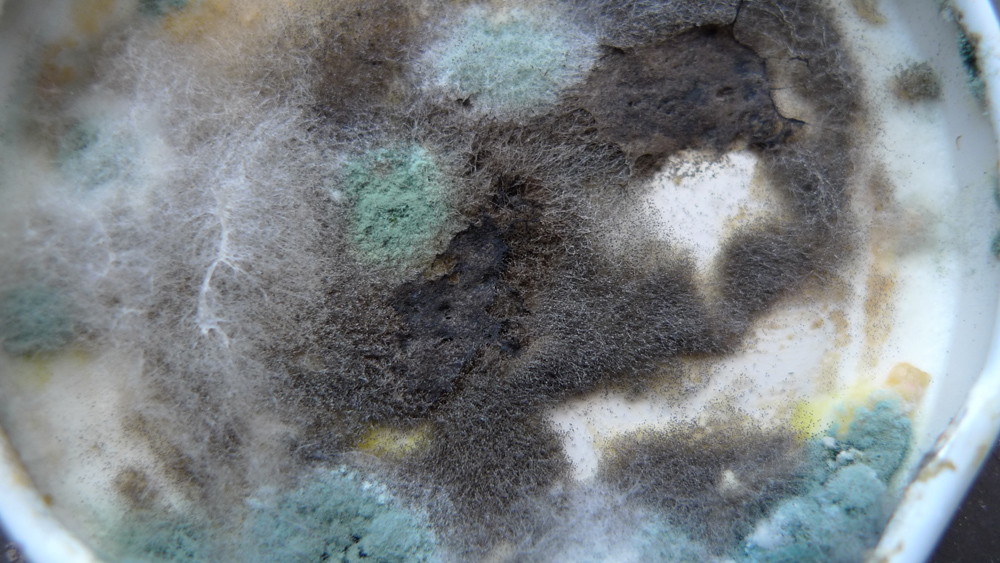
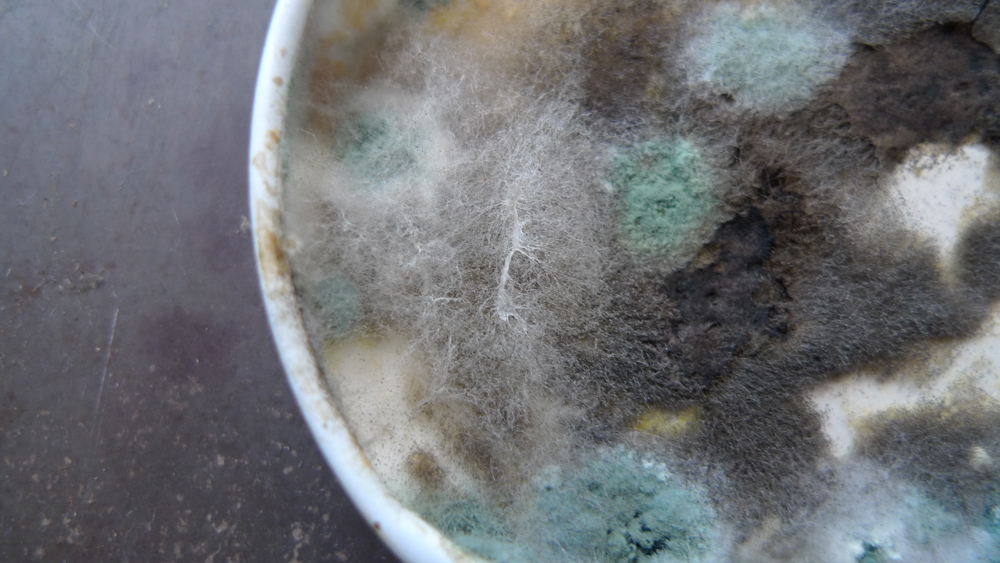
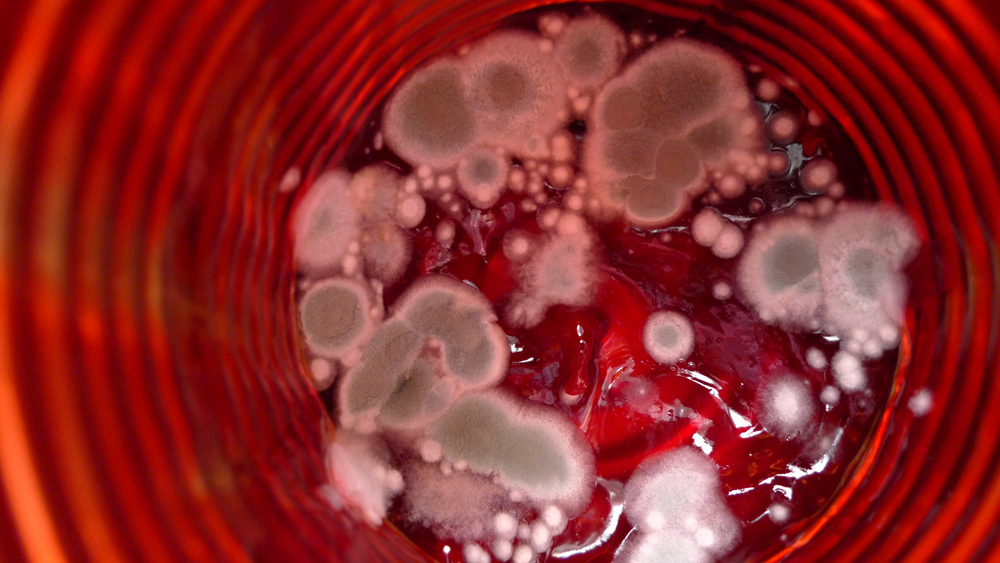

By Antonia Hernández
This photographic essay borrows from Donna Haraway’s expanded concept of ‘companion species’, which addresses interspecies cohabitation within domestic space. Here, rotten food found in the refrigerator becomes a statement that disputes the human-centred organization of the home and gives a new meaning to domestication.
Through my weekly cleaning process, I was made aware of the artificiality of the presumed human-centred organization of the home. Daily or weekly cleaning routines belong to several possible domestic orders of the household and cleaning is certainly one that requires a constant battle against what we call decay. Forms of decay can be seen throughout the household – in the forms of disorder, entropy, and dust. Decay also involves literal decomposition of organic matter, as a result of bacteria or mold. By paying attention to the ecologies of the household, once might also observe decay as the preeminence of organisms habitually marginalized in the domestic ecology through normative acts, such as cleaning. The wonder I encountered in my refrigerator was both beautiful and also part of an indefatigable network able to grow in creative and wise ways.
Specifically, mold is not a particular species nor a category, but a generic name for designate microfungus that have a recognizable spore mass or mycelium. Fungi owe their success to obtaining food from dead organic matter, growing through a complex and decentralized network and by reproducing both sexually and asexually. A network always in movement, where the environment is an active agent. Moreover, by analyzing more things found during the cleaning (for example, a ball of hair from the broom, a dead centipede) I realized that mold was present everywhere, waiting for an opportunity to grow. More active that any other inhabitant of the home, mold is in an intimate relationship with the species that form its environment. It domesticates me, while being domesticated.